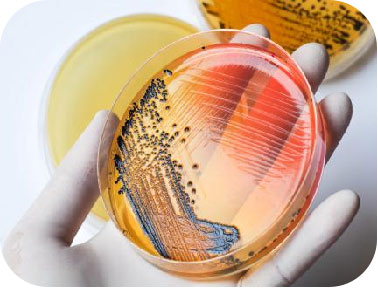
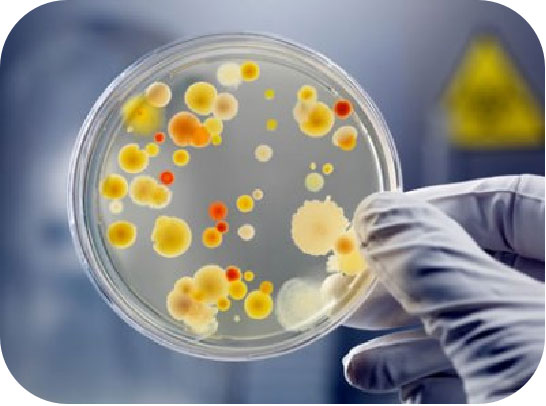

|
Product Name |
BacterAgar™ Premium |
BacterAgar™ Standard |
BacterAgar™ Basic |
BacterAgar™ General |
BacterAgar™ High Clarity |
|---|---|---|---|---|---|
|
Product Code |
BG-01 |
BG-02 |
BG-03 |
BG-04 |
BG-05 |
|
Description |
Highest quality Bacteriological Grade Agar Agar for microbiology |
High quality Bacteriological grade agar |
Good quality Bacteriological grade agar |
Suits for the both plant tissue culture and microbiology |
Specially suits for the ready- to- use agar plates preparation. |
|
Characteristic |
Premium quality with low setting temperature and high gel strength |
Relatively lower setting temperature and good 45℃ water bath performance |
Relatively higher setting temperature and good 45℃ water bath performance |
Competitive price for the general plant tissue culture and microbiology |
High clarity with relatively faster gelling time, suits |
|
Appearance |
Light yellow color, homogenous free flowing powder |
Light yellow, homogenous free flowing powder |
Yellow to light tan homogenous free flowing powder |
Yellow to light tan homogenous free flowing powder |
Light yellow color homogenous free flowing powder |
|
Gel Strength |
950-1050 |
850-950 |
750-850 |
950-1100 |
950-1050 |
|
Loss on drying |
≤ 10% |
≤ 12% |
≤ 15% |
≤ 15% |
≤ 10% |
|
Ash |
≤ 3.0% |
≤ 3.0% |
≤ 5.0% |
≤ 5.0% |
≤ 5.0% |
|
pH |
6.5-7.5 |
6.5-7.5 |
6.5-8.0 |
6.5-8.0 |
6.5-8.0 |
|
Phosphate Precipitation |
No |
No |
No |
No |
No |
|
Alkali Precipitation |
No |
No |
No |
No |
No |
|
Gelling Point |
32-37℃ |
35-38℃ |
37-40℃ |
38-40℃ |
38-41℃ |
|
Melting Point |
80-87℃ |
85-90℃ |
85-90℃ |
85-90℃ |
85-90℃ |
|
Turbidity |
≤7 NTU |
≤10NTU |
≤15 NTU |
≤12 NTU |
≤10 NTU |
|
Recommended Using dosage |
15 –20 g/L |
15 –20 g/L |
15 –20 g/L |
5 – 8 g/L or |
15 –20 g/L |
|
Pack sizes |
20kg, 25Kg |
20kg, 25Kg |
20kg, 25Kg |
20kg, 25Kg |
20kg, 25Kg |
CAS NUMBER: 9002-18-0
SYNONYMS: Agar-agar; Gum agar; Bacto-agar; Bengal gelatin; Bengal ising glass; Ceylon; Ceylon ising glass; Chinese ising glass; Digenea simplex mucilage; GAM medium; Gelose; Japan agar; Japan ising glass; Kantenmatsu; Layor caran; NCI-C50475; Oxoid III; Oxoid L 11; S 100
PRODUCT PROPERTIES AND DESCRIPTION:
Appearance: Light yellow powder with a tan cast
Molecular weight: N/A
BacterAgar™ Bacteriological agar agar series are the gelling agents used in the preparation of culture media and other bacteriological applications. Its main advantage is the absence of inhibitors which could hinder optimal development of microorganisms. In addition, bacteriological agar also possesses other attribute such as transparency, high hysteresis and very reliable reproducibility.
Key Features & Benefits
Guaranteed Purity & Performance: Each batch is biologically tested against known bacterial cultures to ensure the?absence of inhibitors and guarantee optimal, reproducible microbial growth.

Superior Clarity & Transparency: Our agar agar exhibit?low turbidity (as low as ≤7 NTU), providing excellent clarity for easy observation and enumeration of colonies without visual interference.
Precise Gelling Properties: Engineered with specific?gelling and melting points, our agar agar offer excellent hysteresis (the gap between melting and gelling temperatures), ensuring media remains solid at standard incubation temperatures and melts completely for pouring.
Exceptional Gel Strength: Formulated to provide high gel strength even at standard concentrations (1.5%), resulting in stable, firm media surfaces that resist breaking and are easy to handle.
No Precipitate Formation: All our bacteriological grades are tested and confirmed to have?no phosphate or alkali precipitation, preventing cloudiness and ensuring a smooth, clear gel matrix.
|
Items |
Specification |
Test Method |
|---|---|---|
|
Appearance |
Light yellow powder |
Visual |
|
Particle size |
≥ 95% pass 60 mesh |
Screen |
|
Gel Strength (1.5%) |
≥ 950 g/cm² |
Standard Agar Test |
|
Turbidity (1.5% Solution ) |
≤ 7 NTU |
Turbidimeter |
|
pH (1.5% solution) |
6.5 - 7.5 |
In H₂O |
|
Ash Content |
≤ 3.0% |
Muffle Furnace |
|
Starch and Gelatin test |
Negative |
- |
|
Loss on Drying |
≤ 10% |
- |
|
Insoluble matter |
≤ 0.5% |
- |
|
Gelling Temperature (1.5%) |
32 - 37 °C |
- |
|
Melting Temperature (1.5%) |
80 - 87 °C |
- |
|
Phosphate Precipitation |
No precipitation |
- |
|
Alkaline Precipitation(pH8.4+0.1) |
No precipitation |
- |
|
Heavy Metals |
≤ 10ppm |
- |
|
Lead |
≤ 2ppm |
AAS |
Preparation:
Add the weighed quantity of BacterAgar™ BG to your room temperature media solution while stirring vigorously. Heat with constant agitation until the solution becomes completely clear. Autoclave at 121°C for 15-20 minutes. Dispense into culture vessels under sterile conditions.
Storage
Store sealed medium containing Agar Agar at 2 - 30?C. Once opened and recapped, place container in a low humidity environment at the same storage temperature. Protect from moisture and light by keeping container tightly closed.
Expiration
Refer to expiration date stamped on container. Agar Agar should be discarded if not free flowing, or if the appearance has changed from the original color. Expiry applies to Agar Agar in its intact container when stored as directed.
Packing
20 kg or 25kg per drum / carton